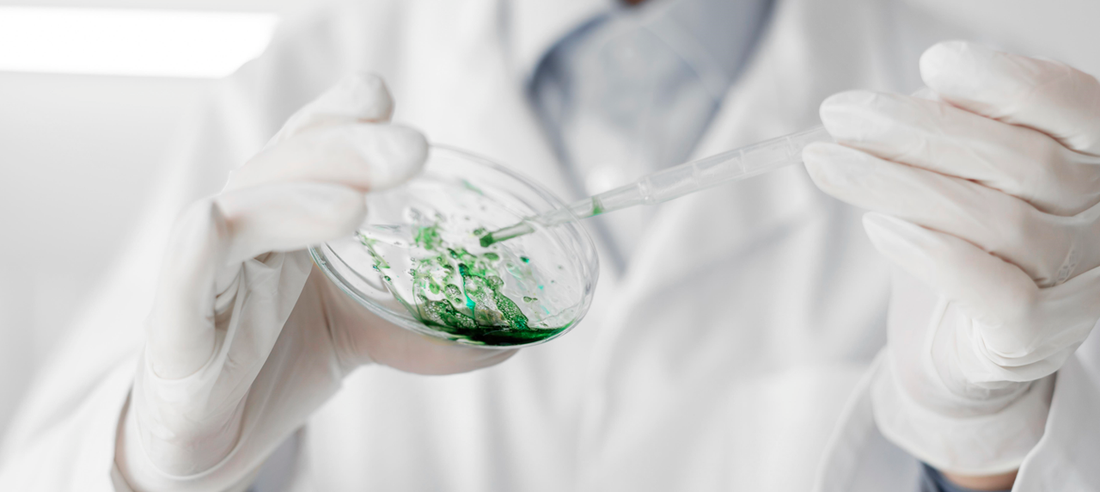

Antibiotic resistance is a growing concern worldwide, driven by the overuse and misuse of antibiotics in medicine and agriculture. Superbugs, resistant to multiple antibiotics, cause infections that are difficult to treat and often lead to severe outcomes. Developing new antibiotics is essential to stay ahead of these evolving pathogens and ensure effective treatment options remain available.
Challenges in Antibiotic Development:
-
Scientific Challenges:
-
Identifying novel compounds that can effectively target resistant bacteria without harming human cells is a complex and time-consuming process.
-
Bacteria can rapidly develop resistance mechanisms, necessitating the continuous search for new and innovative drug targets.
-
-
Economic Challenges:
-
The high cost of antibiotic research and development (R&D), combined with a relatively low return on investment, discourages pharmaceutical companies from investing in new antibiotics.
-
Antibiotics are typically used for short durations, unlike chronic disease medications, reducing potential profits.
-
-
Regulatory Challenges:
-
Stringent regulatory requirements ensure new antibiotics are safe and effective but also prolong the development process.
-
Balancing rapid approval with thorough evaluation is crucial to avoid unintended consequences of new drugs.
-
Strategies for Developing New Antibiotics:
-
Exploring New Sources:
-
Natural products from soil microbes, marine organisms, and plant extracts have historically been rich sources of antibiotics. Advances in biotechnology enable the exploration of these sources more effectively.
-
Synthetic biology and genetic engineering allow for the creation of novel compounds and the modification of existing ones to enhance their efficacy.
-
-
Targeting Resistance Mechanisms:
-
Understanding the mechanisms behind antibiotic resistance can inform the design of drugs that specifically target these pathways.
-
Inhibitors that block resistance enzymes or efflux pumps, used by bacteria to evade antibiotics, can restore the effectiveness of existing drugs.
-
-
Revitalizing Old Antibiotics:
-
Combining old antibiotics with new adjuvants that inhibit resistance mechanisms can rejuvenate their effectiveness against resistant strains.
-
Chemical modifications of existing antibiotics can improve their activity and reduce resistance potential.
-
-
Encouraging Collaborative Efforts:
-
Public-private partnerships, government funding, and international collaborations are essential to pool resources and expertise.
-
Initiatives like the Global Antibiotic Research and Development Partnership (GARDP) and CARB-X support the discovery and development of new antibiotics.
-
Recent Advancements in Antibiotic Development:
-
Teixobactin:
-
Discovered in soil bacteria, teixobactin shows promise against a range of gram-positive pathogens, including MRSA and tuberculosis, by targeting cell wall synthesis.
-
-
Pseudouridimycin:
-
This novel antibiotic inhibits bacterial RNA polymerase, showing efficacy against drug-resistant strains and demonstrating a new mode of action.
-
-
Beta-Lactamase Inhibitors:
-
New beta-lactamase inhibitors, combined with existing antibiotics, protect the antibiotic from degradation by resistant bacteria, restoring their potency.
-
The fight against superbugs requires continuous innovation and investment in antibiotic development. While challenges exist, advances in science and technology, coupled with collaborative efforts, offer hope for the future. By exploring new sources, targeting resistance mechanisms, revitalizing old antibiotics, and fostering partnerships, the medical community can develop effective strategies to combat antibiotic-resistant bacteria.